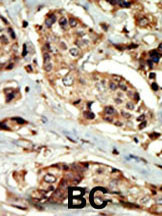

> Antigen, Antibodies, ELISA, Western Blot > Primary Antibody > Polyclonal Antibodies > STK16 Antibody (N-term)Brand |
Leading Biology | Catalog Number |
AMM08586G |
Product Type |
Polyclonal Antibodies | Field of Research |
|
Product Overview |
We constantly strive to ensure we provide our customers with the best antibodies. As a result of this work we offer this antibody in purified format.
We are in the process of updating our datasheets. If you have any questions regarding this update, please feel free to contact our technical support team.
This product is a high quality STK16 antibody (N-term).
|
||
Molecular Weight |
34656 Da
|
||
Cellular Localization |
Antigen Cellular Localization:
Cytoplasm, perinuclear region. Membrane; Lipid-anchor. Note=Associates with Golgi and Golgi-derived vesicles.
|
||
Host |
Rabbit
|
||
Species Reactivity |
Human, Mouse
|
||
Immunogen |
17-46 aa
|
||
Target |
This STK16 antibody is generated from rabbits immunized with a KLH conjugated synthetic peptide between 17-46 amino acids from the N-terminal region of human STK16.
|
||
Isotype |
Rabbit Ig
|
||
Symbol |
MPSK1, PKL12, TSF1
|
||
GeneID |
|||
UniProt ID |
|||
Function |
Membrane-associated protein kinase that phosphorylates on serine and threonine residues. In vitro substrates include DRG1, ENO1 and EIF4EBP1. Also autophosphorylates. May be involved in secretory vesicle trafficking or intracellular signaling. May have a role in regulating stromal-epithelial interactions that occur during ductal morphogenesis in the mammary gland. May be involved in TGF-beta signaling. Able to autophosphorylate on Tyr residue; it is however unclear whether it has tyrosine-protein kinase toward other proteins.
|
||
Summary |
Protein kinases are enzymes that transfer a phosphate group from a phosphate donor, generally the g phosphate of ATP, onto an acceptor amino acid in a substrate protein. By this basic mechanism, protein kinases mediate most of the signal transduction in eukaryotic cells, regulating cellular metabolism, transcription, cell cycle progression, cytoskeletal rearrangement and cell movement, apoptosis, and differentiation. With more than 500 gene products, the protein kinase family is one of the largest families of proteins in eukaryotes. The family has been classified in 8 major groups based on sequence comparison of their tyrosine (PTK) or serine/threonine (STK) kinase catalytic domains. The STE group (homologs of yeast Sterile 7, 11, 20 kinases) consists of 50 kinases related to the mitogen-activated protein kinase (MAPK) cascade families (Ste7/MAP2K, Ste11/MAP3K, and Ste20/MAP4K). MAP kinase cascades, consisting of a MAPK and one or more upstream regulatory kinases (MAPKKs) have been best characterized in the yeast pheromone response pathway. Pheromones bind to Ste cell surface receptors and activate yeast MAPK pathway.
|
||
Form |
Purified polyclonal antibody supplied in PBS with 0.09% (W/V) sodium azide. This antibody is prepared by Saturated Ammonium Sulfate (SAS) precipitation followed by dialysis against PBS. |
||
Storage & Stability |
Store at +4°C short term. For long-term storage, aliquot and store at -20°C or below. Stable for 12 months at -20°C. Avoid repeated freeze-thaw cycles.
|
||
Applications |
WB, IHC-P, E
|
||
Dilution |
WB~~1:1000
IHC-P~~1:50~100
|
||
Synonyms |
Serine/threonine-protein kinase 16, Myristoylated and palmitoylated serine/threonine-protein kinase, MPSK, Protein kinase PKL12, TGF-beta-stimulated factor 1, TSF-1, Tyrosine-protein kinase STK16, hPSK, STK16, MPSK1, PKL12, TSF1
|
||
Images |

The anti-STK16 Pab (Cat. AMM08586G) is used in Western blot to detect STK16 in mouse brain tissue lysate.
Formalin-fixed and paraffin-embedded human cancer tissue reacted with the primary antibody, which was peroxidase-conjugated to the secondary antibody, followed by DAB staining. This data demonstrates the use of this antibody for immunohistochemistry; clinical relevance has not been evaluated. BC = breast carcinoma; HC = hepatocarcinoma. 
Western blot analysis of STK16 (arrow) using rabbit polyclonal STK16 Antibody (S32) (Cat. AMM08586G). 293 cell lysates (2 ug/lane) either nontransfected (Lane 1) or transiently transfected (Lane 2) with the STK16 gene. |
||
Specification |
|||
Quantity |
|
||
| Select | Brand | Catalog No. | Product Name | Pack Size | Type | Field of Research | Specification | Quantity | Price(USD) | |
| 1 | Leading Biology | APR03440G | ITGA11 Antibody (N-term) | 100 μl | Polyclonal Antibodies |
|
$495.00 | Add Ask | ||
| 2 | Leading Biology | APR04537G | CMIP Antibody (C-term) | 100 μl | Polyclonal Antibodies |
|
$495.00 | Add Ask | ||
| 3 | Leading Biology | APR12422G | Human H4 Histamine Receptor (extracellular) Antibody | 50 μl | Polyclonal Antibodies |
|
$695.00 | Add Ask | ||
| 4 | Leading Biology | APR03844G | UBE2W Antibody (C-term) | 100 μl | Polyclonal Antibodies |
|
$495.00 | Add Ask | ||
| 5 | Leading Biology | APR04349G | HECTD2 Antibody (N-term) | 100 μl | Polyclonal Antibodies |
|
$495.00 | Add Ask | ||
| 6 | Leading Biology | APR03502G | IGHG1 Antibody (Center) | 100 μl | Polyclonal Antibodies |
|
$495.00 | Add Ask |
 Leading Biology Inc.
2600 Hilltop DR, Building G, B Suite C138
Richmond, CA, 94806
Tel: 1-661-524(LBI)-0262
Email: info@leadingbiology.com
Leading Biology Inc.
2600 Hilltop DR, Building G, B Suite C138
Richmond, CA, 94806
Tel: 1-661-524(LBI)-0262
Email: info@leadingbiology.com
Complete this form and click send to ask us a question, request a quote or simply say hello.

You have 0 item in your cart

You have 0 item in your inquiry list
